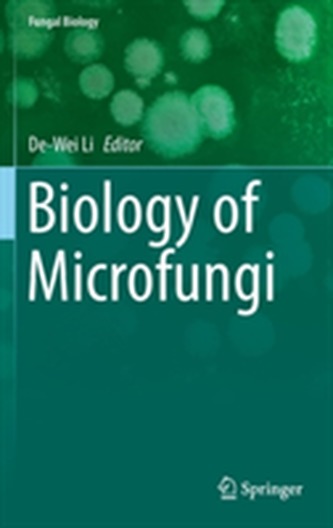

Biology of Microfungi
9
%
4624 Kč 5 091 Kč
Sleva až 70% u třetiny knih
This reference book includes 24 chapters written by a group of experts in the different fields of microfungi and cover a broad range of topics on microfungi.
| Nakladatel: | Springer International Publishing AG |
| ISBN: | 9783319291352 |
| Rok vydání: | 2016 |
| Jazyk : | Angličtina |
| Vazba: | Hardback |
| Počet stran: | 650 |
Mohlo by se vám také líbit..
-

Christiane F. - Můj druhý život (Pokr...
Felscherinow Christiane V., Vukovic Sonja
-

Hyde Park Civilizace
Stach Daniel, Cihlářová Gabriela,
-

Girlboss
Amoruso, Sophia
-

Do hrobu si to nevemu
Karel Šíp
-

William Blake
Ackroyd, Peter
-

Elon Musk
Vance, Ashlee
-

Belmondo o Belmondovi
Belmondo, Jean-Paul
-

Steve Jobs
Walter Isaacson
-

Ze mě
Pavlína Brzáková
-

Životopis jogína
Paramhansa Jógánanda
-

Padrino Krejčíř - Gangster
Kmenta Jaroslav
-

Nezapomeň na zlé časy
Günter K. Koschorrek
-

My Search for Ramanujan
Keniči Sonoda
-

Strategy in Airline Loyalty
De Boer, Evert R.
-

Atlas of Upper Extremity Trauma
Eglseder, W. Andrew
-

Rheumatology in Questions
Moutsopoulos, Haralampos M.; Zampeli, Evangelia; Vlachoyiannopoulos, Panayiotis G.